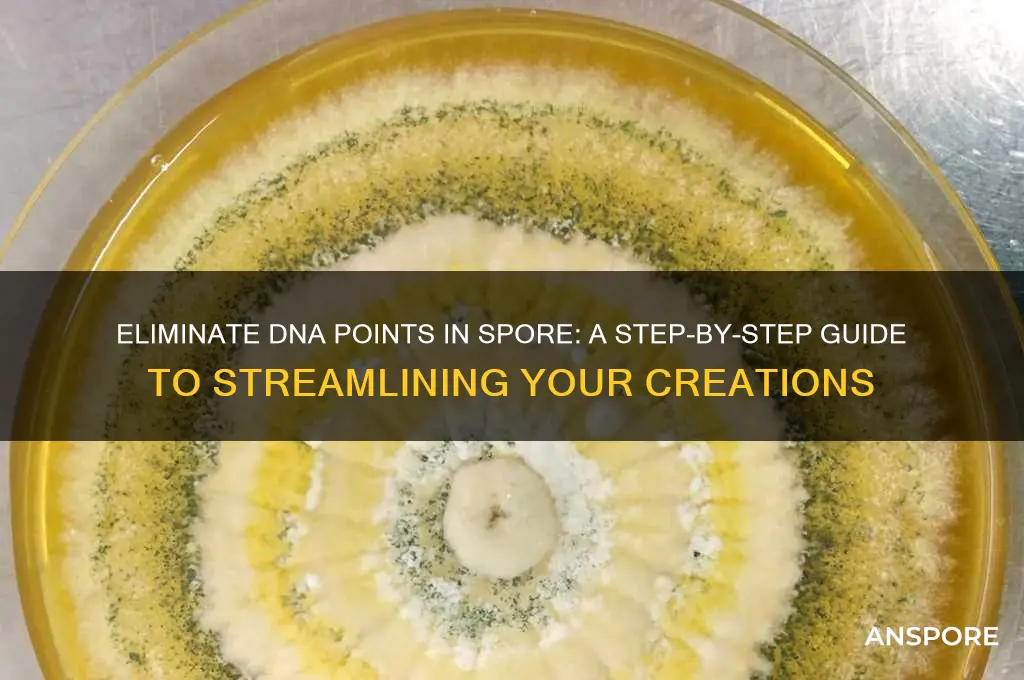
how to get rid of dna points in spore

In *Spore*, DNA points are a crucial resource used to unlock new parts and abilities for your creature, but sometimes players find themselves with excess points they no longer need or want. Getting rid of DNA points can seem tricky since the game doesn’t provide a direct way to discard them. However, players can effectively reduce their DNA points by spending them on unnecessary or redundant creature parts, such as additional limbs or decorative features, or by evolving their creature in a way that doesn’t align with their current design. Another strategy is to save your game and intentionally lose a battle or fail a challenge, as this can sometimes reset or reduce your DNA points, though this method is less reliable. Understanding how to manage or eliminate excess DNA points allows players to maintain a streamlined and purposeful evolution process in *Spore*.
| Characteristics | Values |
|---|---|
| Game Mode | Spore (Cell Stage, Creature Stage, etc.) |
| DNA Points | Points earned by evolving traits in the Creature Editor. |
| Primary Method to Remove DNA Points | No direct method to "remove" DNA points once spent. |
| Workarounds | 1. Reset Creature: Start over in the Creature Editor. |
| 2. Save Scumming: Load an earlier save before spending points. | |
| 3. Mods/Cheats: Use third-party tools (not officially supported). | |
| Official Support | No in-game feature to refund or remove DNA points. |
| Platform Availability | PC, Mac (mods may vary in compatibility). |
| Risk of Workarounds | Save scumming may corrupt saves; mods can cause instability. |
| Alternative Strategy | Plan traits carefully before spending DNA points. |
| Last Verified | Data accurate as of latest Spore updates (2023). |
Explore related products
What You'll Learn
- Edit Creature in Spore Editor: Modify creature's DNA points directly in the editor by adjusting parts and stats
- Use Cheats or Mods: Enable cheats or install mods to reset or remove DNA points effortlessly
- Reload Save Files: Revert to an earlier save file before DNA points were allocated incorrectly
- Start New Creature: Abandon current creature and begin anew to avoid unwanted DNA point distribution
- Max Out Stats First: Allocate all DNA points to stats before adding parts to minimize excess points

Edit Creature in Spore Editor: Modify creature's DNA points directly in the editor by adjusting parts and stats
In the Spore Creature Editor, DNA points act as a budget limiting the complexity of your creations. Every part added or stat adjusted consumes these points, forcing players to balance ambition with the game's constraints. However, by strategically modifying parts and stats directly within the editor, you can effectively "get rid" of excess DNA points, allowing for more intricate designs without hitting the limit prematurely.
Understanding this mechanic is crucial for crafting creatures that are both visually stunning and functionally balanced.
The key lies in recognizing that not all parts and stats are created equal in terms of DNA cost. For instance, a complex limb with multiple joints will consume significantly more points than a simple tail. Similarly, maxing out a creature's speed stat will deplete DNA points faster than making minor adjustments to strength. By prioritizing essential features and making judicious stat tweaks, you can stretch your DNA budget further. Start by adding core structural elements first, then refine details like coloration and secondary features, ensuring you don't overspend early on.
A practical approach involves a two-step process: first, focus on the creature's silhouette and movement by adding primary parts like limbs, heads, and torsos. Use the "Adjust" tool to fine-tune their size and position, which often costs fewer DNA points than adding entirely new components. Second, allocate remaining points to secondary features such as eyes, mouths, and decorative elements. For stats, consider the creature's intended role—a predator might prioritize speed and strength, while a herbivore could benefit from higher health and social stats. This methodical approach ensures every DNA point is spent efficiently.
One often-overlooked technique is leveraging symmetry. Enabling the symmetry mode in the editor allows you to place parts on one side of the creature, automatically mirroring them to the other. This not only saves time but also reduces DNA point expenditure, as mirrored parts count as a single addition. Additionally, experimenting with part scaling can yield surprising results; resizing a part to fit a specific aesthetic can sometimes cost fewer points than adding a new, similarly shaped component.
Finally, don't underestimate the power of trial and error. The Spore editor is forgiving, allowing you to undo changes or start over entirely. If you find yourself running out of DNA points, revisit your design choices. Could a simpler limb achieve the same effect? Are there stats that can be lowered without compromising functionality? By iteratively refining your creature, you can master the art of DNA point management, transforming limitations into opportunities for creativity.
Does Spora Deliver Value When You Pay: A Comprehensive Review
You may want to see also

Use Cheats or Mods: Enable cheats or install mods to reset or remove DNA points effortlessly
Cheats and mods offer a straightforward solution for players looking to reset or remove DNA points in *Spore* without the hassle of grinding or replaying stages. By leveraging these tools, you can bypass the game’s limitations and customize your creature’s evolution to your liking. Whether you’re correcting a design mistake or experimenting with new ideas, cheats and mods provide an efficient workaround to the DNA point system.
To begin, enabling cheats in *Spore* is a simple process. During gameplay, press the tilde key (~) to open the console, then type in commands like `addDNA` or `resetDNA` to manipulate your points. For example, `addDNA -100` will subtract 100 DNA points, allowing you to remove unwanted parts or traits. This method is ideal for quick fixes and doesn’t require additional downloads or installations. However, it’s important to use cheats judiciously, as excessive alterations can disrupt the game’s balance.
For a more comprehensive solution, installing mods can provide greater control over DNA points. Mods like the *Spore DNA Editor* or *Dark Injection* offer advanced features, such as resetting all DNA points or editing specific attributes. To install a mod, download the file from a trusted source, extract it into your *Spore* directory, and activate it through the game’s launcher. While mods require a bit more setup, they often include additional enhancements, such as new parts or improved graphics, enriching your overall gameplay experience.
One cautionary note: using cheats or mods can sometimes lead to unintended consequences, such as save file corruption or compatibility issues with future updates. Always back up your save files before making significant changes, and ensure the mod you’re using is compatible with your version of *Spore*. Additionally, some mods may alter the game’s difficulty or progression, so consider whether these changes align with your desired playstyle.
In conclusion, cheats and mods are powerful tools for managing DNA points in *Spore*, offering both simplicity and depth depending on your needs. Whether you opt for quick console commands or robust mod installations, these methods empower you to shape your creature’s evolution with precision and creativity. By understanding their mechanics and potential risks, you can harness their full potential without compromising your gameplay experience.
Windex and Mold: Can It Effectively Kill Mold Spores?
You may want to see also

Reload Save Files: Revert to an earlier save file before DNA points were allocated incorrectly
One of the most straightforward methods to rectify misallocated DNA points in *Spore* is to reload an earlier save file. This approach leverages the game’s save system to undo mistakes, effectively resetting your creature’s evolution to a point before the incorrect allocation occurred. It’s a fail-safe option that avoids the need for third-party tools or complex workarounds, making it accessible even to casual players.
To execute this method, first locate your *Spore* save files, typically stored in the game’s installation directory under a folder named "Saves." Each save file corresponds to a specific point in your creature’s evolution, so identify the one created before the DNA points were misallocated. Once identified, load this save file from the game’s main menu. This action will revert your creature to its previous state, allowing you to reallocate DNA points correctly.
While this method is effective, it’s not without limitations. If you’ve progressed significantly since the misallocation, reloading an earlier save means losing all subsequent changes, including advancements in later stages of evolution. Additionally, frequent saving is crucial to ensure you have a recent backup to revert to. Players who save infrequently may find this method impractical, as it could force them to redo large portions of the game.
A practical tip is to save your game at key milestones, such as immediately before allocating DNA points or after completing a major evolutionary stage. This habit ensures you always have a recent save to fall back on. For players who prefer a more cautious approach, creating manual backups of save files outside the game directory can provide an extra layer of security.
In conclusion, reloading an earlier save file is a reliable and user-friendly solution for correcting DNA point misallocations in *Spore*. While it requires careful save management and may involve sacrificing progress, its simplicity and effectiveness make it a go-to strategy for players seeking to undo mistakes without external tools. By adopting a disciplined saving routine, you can minimize the impact of errors and maintain control over your creature’s evolution.
Can C. Diff Tests Detect Spores? Unraveling Diagnostic Accuracy
You may want to see also
Explore related products

Start New Creature: Abandon current creature and begin anew to avoid unwanted DNA point distribution
In Spore, DNA points are a precious resource that dictates your creature's abilities and evolution. However, misallocated points can hinder progress, leaving players frustrated. One radical yet effective solution is to start a new creature, abandoning your current creation to reset DNA point distribution. This approach, while drastic, offers a clean slate and the opportunity to strategically allocate points from the outset. It’s a method favored by perfectionists and those who prioritize long-term success over short-term attachment to a flawed design.
The process is straightforward but requires commitment. First, save your current game to avoid losing progress in other stages. Then, return to the Creature Editor and select the option to start a new creature. This action permanently discards your existing creature, so ensure you’re ready to let go. Beginning anew allows you to reevaluate your design choices, focusing on traits that align with your evolutionary goals. For instance, if your previous creature had too many points in social abilities but lacked speed, you can now prioritize mobility without the burden of past mistakes.
While starting over may seem time-consuming, it’s often more efficient than attempting to work around a suboptimal DNA distribution. Players who choose this path report greater satisfaction in later stages, as their creatures are better equipped for challenges like predation or mating. However, this method isn’t for everyone. It demands patience and a willingness to sacrifice progress for precision. Casual players might find it too extreme, but for those aiming for a perfect playthrough, it’s a strategic masterstroke.
A practical tip for those considering this approach is to plan your new creature’s DNA allocation before diving in. Use external resources or notes to outline which abilities and traits you’ll prioritize. This foresight minimizes the risk of repeating mistakes and ensures your new creature aligns with your vision. Additionally, remember that starting over doesn’t erase the lessons learned from your previous attempt. Apply that knowledge to create a creature that’s not just new, but improved.
In conclusion, abandoning your current creature to start anew is a bold but effective way to address unwanted DNA point distribution in Spore. It’s a method that prioritizes long-term success over immediate attachment, offering a fresh start and the chance to build a creature that truly thrives. If you’re willing to embrace the challenge, this approach can transform your Spore experience from frustrating to fulfilling.
Boost Your Spore Blossom Harvest: Proven Tips and Techniques
You may want to see also

Max Out Stats First: Allocate all DNA points to stats before adding parts to minimize excess points
In the intricate world of Spore, managing DNA points efficiently is crucial for creating a well-balanced and powerful creature. One strategic approach to minimize excess DNA points is to max out stats first before adding parts. This method ensures that your creature’s core abilities are fully developed, leaving fewer points to accumulate as you refine its appearance or abilities later. By prioritizing stats, you create a foundation that supports both functionality and adaptability in the game’s evolving stages.
To implement this strategy, follow a systematic process. Begin by allocating all available DNA points to the primary stats: Health, Attack, Speed, and Defense. Each stat has a maximum cap, typically around 100 points, depending on the stage of the game. For example, in the Creature Stage, focus on boosting Health and Attack to survive early encounters, then shift to Speed and Defense as you progress. Avoid adding cosmetic or secondary parts until these stats are maximized, as doing so prevents the accumulation of unused points that often result from haphazard part additions.
A key advantage of this approach is its efficiency. By maxing out stats first, you ensure that every DNA point contributes directly to your creature’s performance. This is particularly useful in stages like the Tribal or Civilization Stage, where stats directly influence your tribe’s or city’s success. For instance, a creature with maxed-out Health can withstand more attacks during tribal conflicts, while one with maxed-out Speed can outmaneuver predators more effectively. This method also reduces the need to backtrack and reallocate points later, saving time and streamlining gameplay.
However, caution is necessary. While focusing on stats first minimizes excess points, it requires careful planning. Avoid over-investing in a single stat early on, as this can leave you vulnerable in other areas. For example, neglecting Defense in favor of Attack might make your creature powerful but fragile. Additionally, be mindful of the game’s progression; some stages introduce new stats or caps, so adapt your strategy accordingly. For instance, in the Space Stage, Social and Tool stats become relevant, so plan to allocate points to these as well.
In conclusion, maxing out stats before adding parts is a practical and effective way to manage DNA points in Spore. It ensures that your creature is optimized for performance while minimizing excess points that could otherwise go to waste. By following this approach, players can create a well-rounded creature capable of thriving in every stage of the game. Remember, balance is key—prioritize stats strategically, and your creature will dominate its environment with efficiency and precision.
Are Magic Mushroom Spores Legal in the UK? Exploring the Law
You may want to see also
Frequently asked questions
DNA points in Spore are used to unlock new parts and abilities for your creature. However, some players may want to remove them to reset their creature's evolution or start fresh without losing progress.
No, you cannot directly delete DNA points. They are tied to your creature's evolution and parts, so removing them requires adjusting your creature's design.
You can reduce DNA points by removing or simplifying parts on your creature. This will free up points but may alter your creature's appearance or abilities.
There is no built-in feature to reset DNA points entirely. You would need to manually remove parts or start a new creature from scratch.
Yes, some mods or cheat codes may allow you to manipulate DNA points, but this is not officially supported and may affect gameplay stability. Always back up your save files before using mods.



















